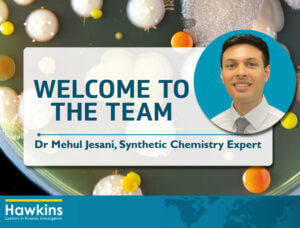

Cargo liquefaction may occur if the material properties of ores or other bulk cargoes are not investigated sufficiently prior to loading, or the IMSBC requirements are not met. Liquefaction can lead to a loss of stability in the cargo, upsetting the trim of the vessel. Extreme cases can cause capsize and foundering.
WHAT IS LIQUEFACTION?
Ores obtained from the mines consist of materials with a wide particle-size distribution, which will affect the material behaviour of the cargo within the holds (see Figure 1 below). In general, larger particles cannot retain much water and will settle together with greater voids between them, whilst smaller particles (fines) are in greater contact with each other due to their increased surface area, and therefore retain more water.

During the voyage, the cargo can respond to vibrations by undergoing compaction. When this happens, the pressure of the water between the particles (pore pressure) can increase, causing the particles eventually to repel each other and start moving (see Figure 2 below). At this point, the solid and liquid material will separate, and the cargo is considered to have liquefied. Once the separation has occurred, it is not possible for the cargo to revert to its original particle configuration. Fine particles are more likely to undergo compaction to a greater extent than larger particles.

STEPS TO PREVENT LIQUEFACTION
Prior to loading, a representative sample containing the range of particle sizes present in the cargo should be sent to an accredited laboratory for moisture content and flow moisture point (FMP) determination. The transportable moisture limit (TML) can be calculated from the FMP and as per the requirements of the IMSBC code, the moisture content should not exceed the TML. If the moisture content is at or above the TML, then the cargo should be declared unsafe and rejected. It is important to note that the moisture content determination of the cargo must be carried out no more than seven days before loading commences. Further, if there has been significant rain between the time of testing and loading, then new tests must be conducted to ensure that the moisture content of the cargo is still below the TML (Section 4.5.2 of the IMSBC Code).
There are three test methods that can be used to determine the FMP: the flow table method, the penetration test, or the Proctor-Fagerberg method. The flow table method is more commonly used, but has a limitation in that the particle size of the material being tested must be less than 7mm. As such, stones and larger material have to be removed prior to testing the sample. Similarly, the Proctor- Fagerberg test has a size limitation of 5mm. The penetration test requires larger sample sizes, but allows material with a particle size of up to 25mm. As the laboratories in South East Asia tend to conduct the flow table test only, it is imperative to ensure that the material has been sieved appropriately prior to conducting the test in order to produce accurate data.
At Hawkins we can provide advice on suitable sampling methods and appropriate laboratory conduct, both of which will assist in determining whether or not the cargo is safe for loading.
ABOUT THE AUTHOR
Dr Sophie Parsons is a Chartered Engineer (CEng) and a Professional Member of the Institute of Materials, Minerals, and Mining (MIMMM). She has been involved in numerous liquefaction cases and associated laboratory testing for determining the flow point and moisture content of cargo. In addition to her casework, Sophie regularly presents to law firms, P&I Clubs and loss adjusting companies on materials failure analysis and corrosion.